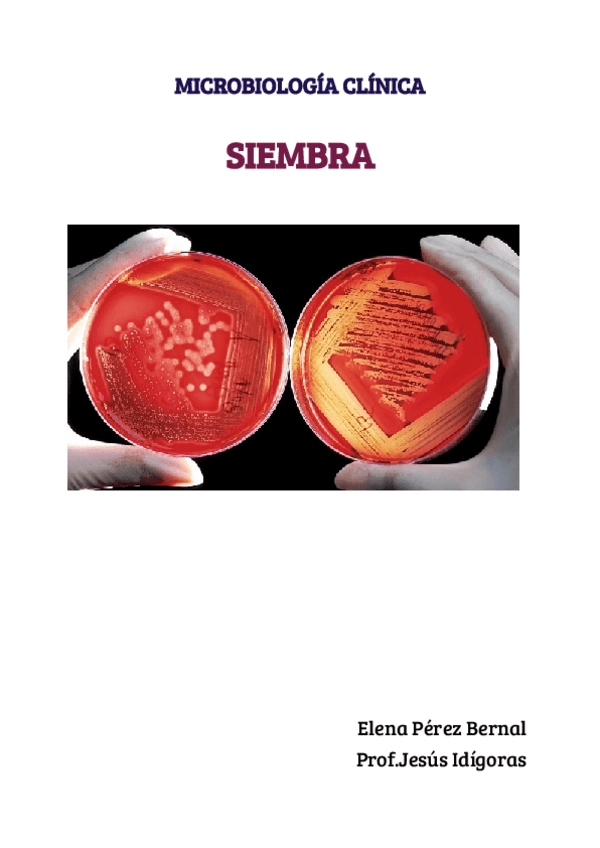

Microbiología clínica
He publicado nuevos trabajos de Microbiología clínica: Presentacion-Microbiologia.-Parasitologia..pdf
He publicado nuevos apuntes de Microbiología clínica: resumen-teorico-practica-de-cultivos.pdf
He publicado nuevos apuntes de Microbiología clínica: Apuntes-Practicas-Microbiologia.pdf
He publicado nuevos apuntes de Microbiología clínica: Tipos-de-bacterias.pdf
He publicado nuevos trabajos de Microbiología clínica: La-Identificacion-de-Levaduras.pdf
apuntes
-
Teoría Microbiología
Todo lo que se subraya en clases
He publicado nuevos ejercicios de Microbiología clínica: Ni-de-aqui-ni-de-alli.pdf
He publicado nuevos practicas de Microbiología clínica: Identificacion-de-fosas-nasales.pdf
He publicado nuevos practicas de Microbiología clínica: Diluciones-seriadas-y-escala-de-mcfarland.pdf
He publicado nuevos practicas de Microbiología clínica: Tincion-diferencial-y-simple.pdf
He publicado nuevos apuntes de Microbiología clínica: PRACTICA-DE-SIEMBRA.pdf
He publicado nuevos ejercicios de Microbiología clínica: Embriones-Triploides-Rescatados-o-no.pdf
He publicado nuevos ejercicios de Microbiología clínica: Clasificacion-Embrionaria.pdf
He publicado nuevos apuntes de Microbiología clínica: Microbiologia-clinica-I.pdf
He publicado nuevos apuntes de Microbiología clínica: MICROBIOLOGIA-II.pdf
practicas
-
Prácticas microbiología
He publicado nuevos practicas de Microbiología clínica: Prácticas microbiología
He publicado nuevos ejercicios de Microbiología clínica: Articulo-Calidad-Seminal.pdf
apuntes
-
Microbiología Tema 3 1ªy2ª parte
He publicado nuevos apuntes de Microbiología clínica: Microbiología Tema 3 1ªy2ª parte
apuntes
-
Esquemas y resumenes
Resúmenes de los temas jej
He publicado nuevos trabajos de Microbiología clínica: Causas-de-Esterilidad.pdf
He publicado nuevos practicas de Microbiología clínica: Esquema-Microbiologia-.pdf
apuntes
-
Acts y tablas Microbiologia
He publicado nuevos apuntes de Microbiología clínica: Acts y tablas Microbiologia
He publicado nuevos apuntes de Microbiología clínica: TEMA-4-MICROBIOLOGIA-IDENTIFICACION.pdf
He publicado nuevos apuntes de Microbiología clínica: MICROBIOLOGIA-TEMA-2.pdf
apuntes
-
Prácticas microbiología
Importantes para el examen práctico
He publicado nuevos apuntes de Microbiología clínica: TEMA-2-MICROBIOLOGIA.pdf
He publicado nuevos ejercicios de Microbiología clínica: Actividades-Tinciones.pdf
ejercicios
-
Actividades Micro
Cositas que pueden caer en los exámenes
apuntes
-
Micro Primer Trimestre
He publicado nuevos apuntes de Microbiología clínica: Micro Primer Trimestre
apuntes
-
Microbiología Primer Trimestre
He publicado nuevos apuntes de Microbiología clínica: Microbiología Primer Trimestre
apuntes
-
MICROBIOLOGÍA CLÍNICA
He publicado nuevos apuntes de Microbiología clínica: MICROBIOLOGÍA CLÍNICA
apuntes
-
Apuntes
He publicado nuevos apuntes de Microbiología clínica: Apuntes
He publicado nuevos practicas de Microbiología clínica: CUADERNO-DE-PRACTICAS-1er-trimestre.pdf

¡Estás al día!
Has visto todos los archivos